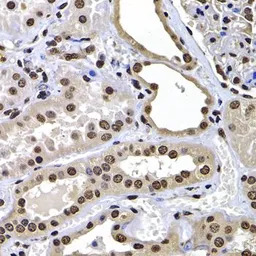
产品细节图片2

相关产品推荐更多 >
万千商家帮你免费找货
0 人在求购买到急需产品
- 详细信息
- 文献和实验
- 技术资料
- 免疫原:
Recombinant fusion protein containing a sequence corresponding to amino acids 123-372 of human H2AFY (NP_613258.2).
- 亚型:
IgG
- 形态:
Liquid
- 保存条件:
Store as concentrated solution. Centrifuge briefly prior to opening vial. For short-term storage (1-2 weeks), store at 4ºC. For long-term storage, aliquot and store at -20ºC or below. Avoid multiple freeze-thaw cycles.
- 克隆性:
Polyclonal
- 标记物:
Unconjugated
- 适应物种:
Human, Mouse, Rat
- 保质期:
12 months from the shipping date of the product.
- 抗原来源:
Human
- 目录编号:
GTX32709
- 级别:
Primary Antibodies
- 库存:
Available
- 供应商:
GeneTex
- 宿主:
Rabbit
- 应用范围:
WB, ICC/IF, IHC-P
- 浓度:
Batch dependent (Please refer to the vial label for the specific concentration.)
- 靶点:
Macro H2A.1
- 抗体英文名:
Macro H2A.1 antibody
- 抗体名:
Macro H2A.1 抗体
- 规格:
100 μl

ICC/IF analysis of U2OS cells using GTX32709 Macro H2A.1 antibody.
Blue : DAPI
IHC-P analysis of human kidney tissue using GTX32709 Macro H2A.1 antibody.
Dilution : 1:100

IHC-P analysis of mouse lung cancer tissue using GTX32709 Macro H2A.1 antibody.
Dilution : 1:100

IHC-P analysis of human stomach tissue using GTX32709 Macro H2A.1 antibody.
Dilution : 1:100

WB analysis of various sample lysates using GTX32709 Macro H2A.1 antibody.
Dilution : 1:1000
Loading : 25μg per lane

IHC-P analysis of human kidney cancer tissue using GTX32709 Macro H2A.1 antibody.
Dilution : 1:100

WB analysis of normal (control) and knockout (KO) 293T cell lysate using GTX32709 Macro H2A.1 antibody.
Dilution : 1:1000
Loading : 25μg per lane
风险提示:丁香通仅作为第三方平台,为商家信息发布提供平台空间。用户咨询产品时请注意保护个人信息及财产安全,合理判断,谨慎选购商品,商家和用户对交易行为负责。对于医疗器械类产品,请先查证核实企业经营资质和医疗器械产品注册证情况。
 文献和实验
文献和实验procedure for subtyping the NA glycoprotein is critical for the identification and classification of avian influenza (AI) viruses. The macro-procedure was first described in 1961 by D. Aminoff et al. [2 ] and was later modified to a microtiter plate
Evaluation of the Cardiac Isoform of 2-Macroglobulin as a Factor Inducing Cardiac Hypertrophy
is a cardiac isoform of α2 -macroglobulin belonging to the macro-globulin family. Furthermore, it has been demonstrated that direct injection of the purified 182-kDa protein intravenously (through the tail vein) into the normal animals led to the development
TBS 和 5% NGS 中封闭样品。市售的含有酪蛋白的封闭溶液与磷酸化的一抗结合后易减弱信号;因此,我们建议不使用含有酪蛋白的封闭剂进行磷酸化特异性抗体的检测。以上针对封闭步骤所提建议均是在以 SignalStain. Boost IHC Detection Reagent 作为检测试剂的情况下提出的。如果选择使用其他检测试剂,我们则建议使用与二抗来源相同的血清进行封闭。抗体:Phospho–Histone H2A.X (Ser139) (20E3) Rabbit mAb #9718样本:石蜡
 技术资料
技术资料暂无技术资料 索取技术资料





![Neurotrophin 4 antibody [31A1]](https://img1.dxycdn.com/2022/0328/938/0795621945689400453-14.jpg!wh200)

![Integrin beta 1 / CD29 antibody [MEM-101A] (PE)](https://img1.dxycdn.com/2022/0328/286/4262590928316500453-14.jpg!wh200)
![Histone H2A.Z antibody [RM215]](https://img1.dxycdn.com/2022/0329/967/7811748592155020453-14.jpg!wh200)


